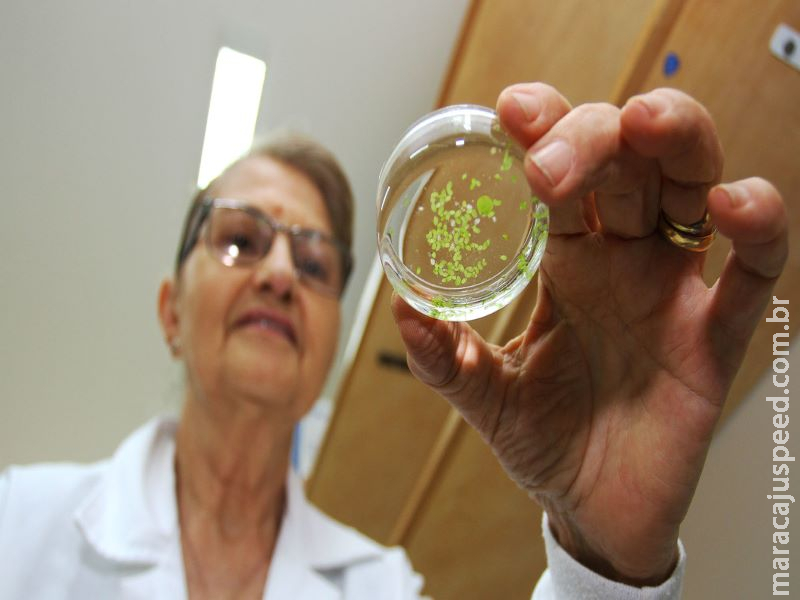
Mais da metade dos pesquisadores de Mato Grosso do Sul são mulheres

Em Mato Grosso do Sul as mulheres representam 58,3% no total de pesquisadores e somam 13.106.
Mulheres que se destacam pela ciência tem sido pauta desde o início do mês de março, quando pesquisadoras sequenciaram o genoma do coronavírus, o Covid-19 apenas 48 horas após a identificação do primeiro caso da doença no Brasil. Apesar da grande visibilidade, o fato não é raro, e o número de mulheres pesquisadoras e cientistas é inspirador não apenas pelo fato de pertencerem ao sexo “frágil”, mas especialmente, pelo grau de relevância de pesquisas coordenadas por elas.
Em Mato Grosso do Sul as mulheres representam 58,3% no total de pesquisadores e somam 13.106 conforme dados gerais da Fundação de Apoio ao Desenvolvimento do Ensino, Ciência e Tecnologia de MS (Fundect), que consideram desde a iniciação cientifica ao pós-doutorado. Fonte infinita de recursos para diversos fins científicos, a flora de Mato Grosso do Sul é a base de estudos de pesquisadoras sul-mato-grossenses, em especial de três mulheres que coordenam grupos que estudam todo potencial existente na castanha de caju, no tucum e na guavira.
Liderado pela Professora Doutora Alexeia Barufatti, um grupo de seis pesquisadores da Universidade Federal da Grande Dourados (UFGD) desenvolveu um detergente à base do líquido da casca da castanha do caju, que em contato com a água, elimina as larvas do mosquito da dengue. Já patenteado, o produto é capaz de matar as larvas em até três horas de ação. O trabalho agora espera que alguma empresa se interesse em inserir o princípio ativo nos detergentes convencionais. Sobre o protagonismo feminino na pesquisa, Alexeia destaca: “É muito importante a luta das mulheres para que possam fazer a sociedade avançar com descobertas e inovações nas diversas áreas de conhecimento seja na matemática, física, química, biologia ou demais áreas”.
Outro fruto nativo estudado por um grupo de pesquisadores da Universidade Federal de Mato Grosso do Sul (UFMS) formado 80% por mulheres, é o tucum, encontrado em abundância na região Pantaneira. A pesquisa, coordenada pela nutricionista doutora em Ciências da Cirurgia, Elisvânia Freitas dos Santos, identificou que não existia nenhum estudo sobre as atividades farmacológicas do produto, que possui grande quantidade de compostos bioativos, o que pode ser de grande ajuda no combate e tratamento de doenças cardiovasculares, diabetes e até câncer. Elisvânia fala orgulhosa do grupo de pesquisa que conta com 15 pesquisadoras. “Me sinto feliz, realizada e motivada à inspirar outras mulheres”.
Fruto símbolo do Mato Grosso do Sul, a guavira é uma rica fonte de pesquisa para um grupo coordenado pela professora doutora Claudia Andrea Lima Cardoso, atualmente, chefe da Divisão de Pós-graduação da Universidade Estadual de Mato Grosso do Sul (UEMS). De nome científico Campomonesia Adamantium, a guavira também conhecida como gabiroba, possui atividades biológicas em seus frutos e em suas folhas, muito utilizadas pela população no tratamento de enfermidades. Entre os mais de 50 estudos desenvolvidos pelos estudiosos, foi comprovado o potencial anti-inflamatório do fruto. “Como mulher sempre tive vontade de quebrar barreiras e esta oportunidade foi intensificada na Universidade. Por minha felicidade encontrei em meu caminho mulheres maravilhosas e guerreiras incansáveis com sede de conhecimento e de transformar a ciência em algo útil e produtivo para a sociedade”, destaca a pesquisadora.
Inspiração
Reconhecida mundialmente por sua atuação no campo da ciência, em especial na área de Botânica, Dra. Vali Joana Pott (capa), contabiliza mais de 40 anos de contribuição com estudos de flora em Mato Grosso do Sul, que renderam diversos livros, entre eles o “Plantas Aquáticas do Pantanal” de 400 páginas, que segundo ela, foi a realização de um sonho.
Fundou o herbário de Corumbá, e desde 2008 atua no herbário CGMS da Universidade Federal de Mato Grosso do Sul (UFMS), sendo os últimos quatro anos como voluntária, onde se dedica a identificar o nome científico das plantas. Recebeu em 2018 o título de Doutora Honoris Causa pela UFMS. Apesar dos 73 anos, ela é incansável. O amor pela pesquisa faz com que continue fazendo história na ciência. “A lista da Flora do Brasil 2020, eu fiz as aráceas -família de planta com flor – para o Brasil. Logo que assumi o compromisso, fiz a minha parte e já finalizei”, conta.
Avanço
De maneira geral, a participação feminina nas universidades e nos laboratórios tem avançado. As mulheres representam 55,2% dos alunos que ingressam no ensino superior, e 61% dos que graduam, conforme o Ministério da Educação. Desde 2003 são maioria em numero de doutores e em 2017 atingiram o patamar de 54% dos titulados. Entre os bolsistas da Coordenação de Aperfeiçoamento de Pessoal de Nível Superior (Capes), elas também são maioria e representam 60% do total de beneficiários na pós-graduação e nos programas de formação de professores.













Olá, deixe seu comentário!Logar-se!